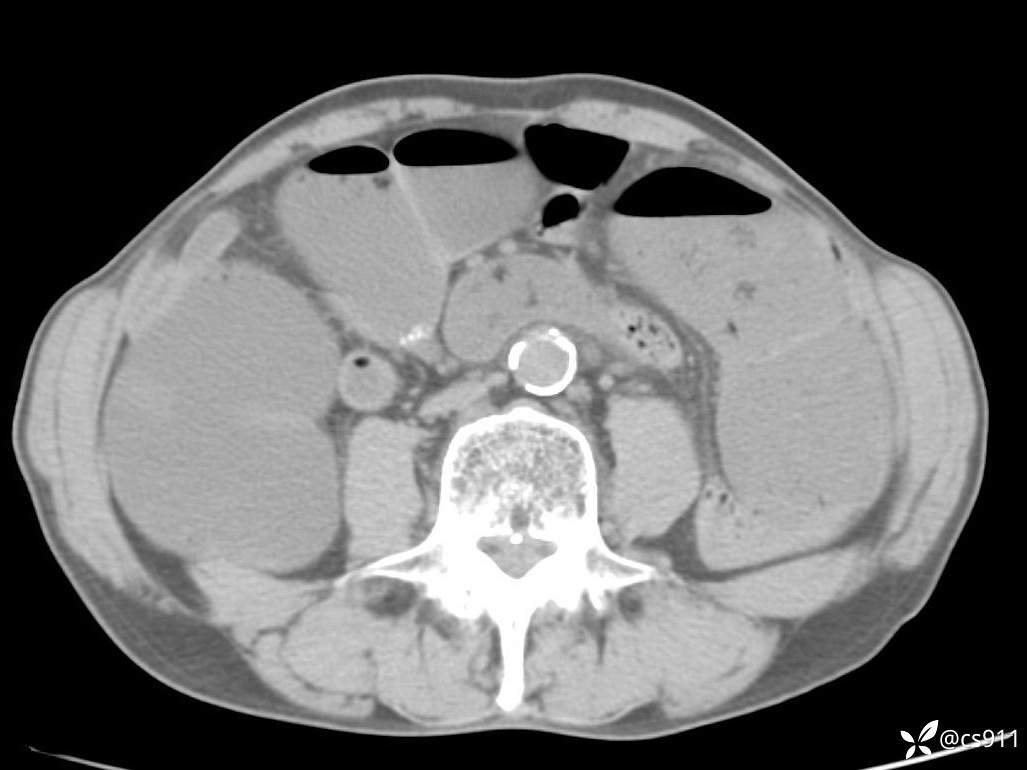
img

急腹症之急诊CT,原因?答案公布
男,77岁,腹痛、腹胀伴恶心呕吐1天。呕吐胃内容物,非喷射性呕吐,有咖啡色样胃内容物,诉有胃穿孔病史。查体:全腹平,下腹部压痛,全腹无反跳痛,叩诊呈浊音,移动性浊音阴性,肠鸣音减弱,1-2次/分。肛检:直肠未扪及明显肿物,可触及大量粪块。
T 36.6℃ P 80次/分 R 26次/分 BP 100/60mmHg
白细胞(WBC) H 14.55 10e9/L 4-10
红细胞(RBC) 4.58 10e12/L 4.3-5.8
中性粒细胞百分率(NEUT%) H 85.7 % 40-75
血淀粉酶(AMY) HH 1859 U/L 35-135
癌胚抗原(CEA) H 27.44 ng/ml 0-5
呕吐物 潜血试验 * 阳性 阴性
患者轮椅入室检查神志清楚, 能配合摆位和呼吸